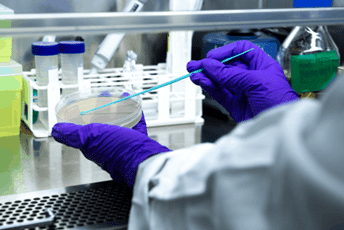
Laboratory testing for technical validation of cleaning solutions generated by an electrolytic cell

What was the challenge or problem to be solved?
Cleaning and disinfection of delicate floors require balancing microbiological effectiveness with material preservation. Continuous use of conventional chemical products may lead to surface alterations or progressive degradation.
In this context, it was necessary to objectively assess whether a solution based on electrolysed water generated by an electrolytic cell could deliver performance equivalent to commercial products, while ensuring greater compatibility with the substrate.
Benchmarking of cleaning products for delicate floors
The project was framed within a benchmarking of cleaning products focused on sensitive surfaces, characterized by specific coatings, protective finishes, or materials with low tolerance to aggressive agents.
The context required comparing commonly used commercial solutions with an alternative generated in situ. This comparison had to be conducted under homogeneous criteria, avoiding biases related to differences in concentration, application method, or contact time.
Comparing solutions under homogeneous conditions is key to avoiding biased conclusions and obtaining truly comparable results.
Beyond determining which option offered higher initial disinfectant capacity, the objective was to understand the overall behavior of each product on the substrate. This involved evaluating potential cumulative effects after repeated applications, functional stability, and consistency of performance. The expected benefit was to obtain a clear comparative matrix to support data-driven decisions rather than relying on commercial claims.
Evaluation of disinfectant efficacy under controlled conditions
The evaluation of disinfectant efficacy was designed to reproduce realistic usage conditions under controlled experimental settings. Measuring theoretical parameters or nominal concentrations of active agents was not sufficient; it was essential to verify effective performance on the surface.
Protocols were defined to quantify microbiological reduction in a reproducible manner, comparing each solution under equivalent conditions. In addition to immediate efficacy, the consistency of results across different operational scenarios was analyzed.
This approach made it possible to identify relevant differences between alternatives that might initially appear equivalent. The critical analysis avoided assuming that higher concentration necessarily implied better performance, incorporating variables such as chemical stability and behavior in contact with the material.
Compatibility with delicate floors and technical validation challenge
Compatibility with delicate floors was one of the central pillars of the project. Certain chemical formulations may cause gloss changes, micro-surface alterations, degradation of protective coatings, or chromatic modifications after repeated application cycles.
The technical challenge lay in designing a protocol capable of detecting subtle variations that are not always evident in initial visual inspections. Surface characterization techniques were integrated with comparative criteria to assess material evolution after successive exposures. To analyze potential cumulative wear effects, an abrasion testing device was incorporated, enabling controlled friction simulation and quantification of variations in surface behavior.
Minor surface alterations can evolve into critical failures after repeated cleaning cycles.
INFINITIA approached this analysis from an independent perspective, avoiding premature conclusions and cross-checking results against objective parameters. The complexity of the study did not rely solely on measuring isolated variables, but on interpreting their combined impact on floor service life. This approach made it possible to assess not only immediate technical feasibility, but also medium- and long-term implications.
How was it addressed or what was the solution?
The project was structured through a comparative methodology combining physicochemical characterization, functional testing, and surface behavior analysis. The approach adopted by the INFINITIA team, bringing together product development and materials innovation, prioritized experimental consistency and traceability of results.
The objective was not to validate a preconceived solution, but to generate objective evidence to identify advantages, limitations, and optimal application conditions for each alternative.
Electrolytic cell for generating disinfectant solutions
The alternative evaluated was produced using an electrolytic cell for generating disinfectant solutions, capable of producing an active agent from water and salts under controlled operating conditions.
From a technical standpoint, it was necessary to characterize the generated solution, determining parameters such as composition, stability, and consistency over time. In situ generation introduces variables associated with operational conditions, making process repeatability verification essential.
In addition, the influence of potential production variations on final performance was assessed. This analysis made it possible to determine to what extent the electrochemical system provided sufficient stability to compete with standardized commercial formulations.
Technical validation of cleaning solutions through comparative analysis
Technical validation of cleaning solutions was carried out through a structured comparative analysis. An experimental set-up was designed to ensure homogeneous application, contact times, and testing conditions for all evaluated alternatives.
The INFINITIA team integrated microbiological testing with evaluations of material condition after repeated application cycles. This approach enabled detection of differences that may not emerge in short-term, isolated assessments.
A well-defined experimental set-up ensures reproducibility and reliability in comparative results.
Critical analysis of the data prevented oversimplified conclusions. In some scenarios, performance was equivalent, while in others differences appeared linked to specific usage conditions. This approach allowed clear operational limits to be defined for each solution.
Sustainable alternative to conventional chemical disinfectants
The potential as a sustainable alternative to conventional chemical disinfectants was also assessed. In situ generation reduces transportation and storage requirements for concentrated products, potentially improving logistics and lowering handling-related risks.
However, sustainability had to be evaluated alongside technical performance. An environmentally favorable solution that is less effective or less compatible with the material would not be viable in demanding environments.
The study identified the conditions under which the evaluated alternative could be safely and efficiently integrated, providing objective technical criteria for a potential transition. The conclusion was not based on a single variable, but on the balanced integration of efficacy, stability, and surface compatibility.




